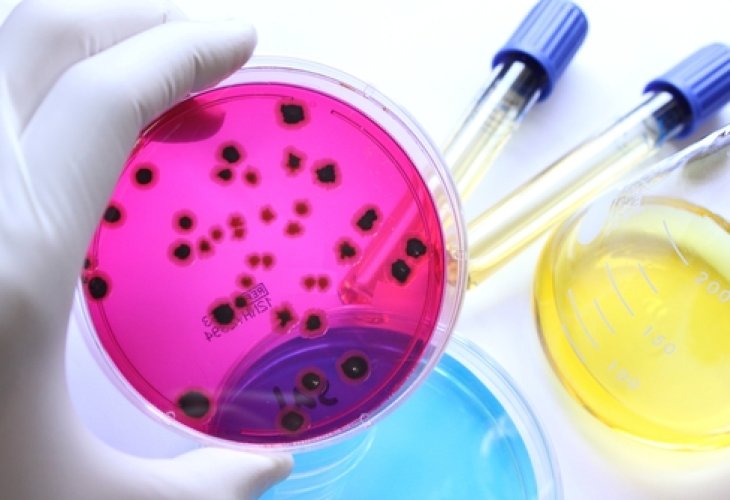

Depression and Anxiety
How Gut Bacteria Affect Your Mood, Cravings, and Health: The Power of the Human Microbiome
New research reveals how trillions of gut microbes influence emotional well-being, eating habits, and even chronic disease risk.
Bacteria in laboratory dishes (Photo: shutterstock)
Bacteria in laboratory dishes (Photo: shutterstock)Recent research in the field of microbiology is shedding new light on how gut bacteria affect many aspects of our lives, including disease prevention, weight loss, and even our mood.
Until now, we haven’t had a clear explanation for why there are days when we seem to devour everything in the fridge without control, or fall into sadness for no apparent reason. Researchers from the University of Florida now suggest that this could be explained by the connection between the nervous system, the immune system, and the digestive system.
According to the study, out of the 100 trillion bacteria residing in the human body, most live quietly and peacefully in our digestive system. Science refers to these “hidden partners” living within us as the human microbiome- a collective term for all the microorganisms in our body. These include fungi, viruses, and bacteria, with those in the digestive system specifically referred to as the flora or microbiota.
Millions of bacteria in our gut feed on what we eat and drink. Studies of their activity mainly focus on how they influence human conditions such as obesity, weight loss, mental disorders and depression, heart disease, and more. Now researchers claim that these bacteria not only influence our cravings and the release of essential bodily chemicals, but also help regulate hormones and affect blood sugar levels.
Scientists believe the microbiome has a far-reaching impact on our eating habits. When we reach for that chocolate bar or salty snack, it's not random- our gut bacteria may actually be demanding that specific food.
Following these groundbreaking studies, researchers hope to uncover even more information about the microbiome and the interactions between these microscopic organisms living within us, and to eventually develop new treatments for currently incurable diseases.


